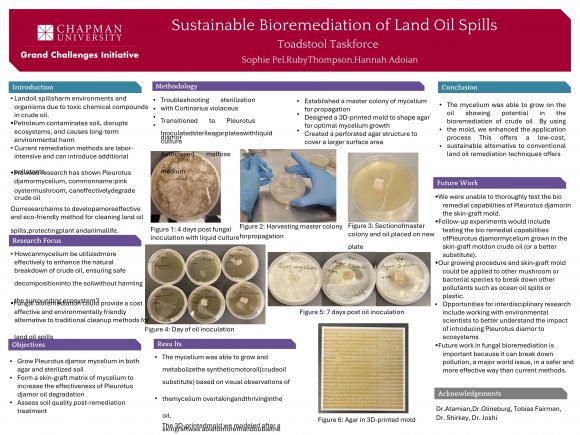

Sustainable Bioremediation of Land Oil Spills Sophie Pel, Ruby Thompson, Hannah Adoian
May 16, 2025
At our 2025 GCI Spring Showcase, a group of students presented a poster about how mushrooms, specifically, Pleurotus djamor mycelium can be used as a more effective and eco-friendly method of cleaning oil spills.